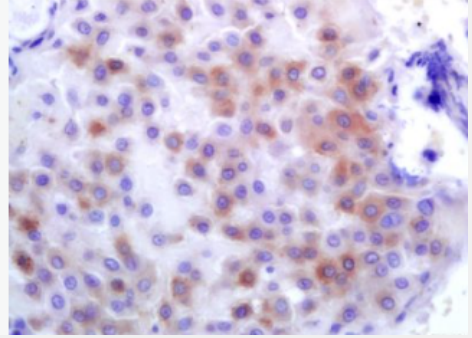
Anti-PLK1 antibody-丝氨酸/苏氨酸蛋白激酶PLK1抗体

Anti-PLK1 antibody-丝氨酸/苏氨酸蛋白激酶PLK1抗体
PLK1
¥1138
50ul
起订
¥1880
100ul
起订
¥2900
200ul
起订
上海 更新日期:2026-04-03
产品详情:
- 中文名称:
- Anti-PLK1 antibody-丝氨酸/苏氨酸蛋白激酶PLK1抗体
- 英文名称:
- PLK1
- 品牌:
- 沪震生物
- 产地:
- 中国/上海
- 保存条件:
- -20°C
- 纯度规格:
- > 99%
- 产品类别:
- 抗体 一抗
- 抗体名:
- PLK 1; PLK; polio like kinase; Polo like kinase 1; Polo-like kinase 1; Serine/threonine protein kinase 13; Serine/threonine protein kinase PLK1; Serine/threonine-protein kinase; STPK 13; STPK13; Polo like kinase kinase; Cell cycle regulated protein kinase; PLK-1; PLK1_HUMAN.
- 靶点:
- 详见说明书
- 宿主:
- Rabbit
- 适应物种:
- 详见说明书
- 克隆性:
- 详见说明书
- 浓度:
- 1mg/ml
- 应用范围:
- WB=1:500-2000 ELISA=1:5000-10000 IHC-P=1:100-500 IHC-F=1:100-500 ICC=1:100-500 IF=1:100-500 (石蜡切片需做抗原修复) not yet tested in other applications. optimal dilutions/concentrations should be determined by the end user.
- 标识物:
- 详见说明书
- 形态:
- 液体
- 亚型:
- IgG
- 免疫原:
- 详见说明书
- 货号:
- Hz-R3535
- 用途范围:
- 科研使用
- 规格:
- 50ul/100ul/200ul
- 是否进口:
- 否
- 是否单克隆:
- 详见说明书
- 保质期:
- 12个月
- 抗原来源:
- 详见说明书
- 标记物:
- 详见说明书
- 产品用途:
- WB=1:500-2000 ELISA=1:5000-10000 IHC-P=1:100-500 IHC-F=1:100-500 ICC=1:100-500 IF=1:100-500 (石蜡切片需做抗原修复) not yet tested in other applications. optimal dilutions/concentrations should be determined by the end user.
公司简介
上海沪震实业有限公司是一家集研发、生产和销售于一体的生命科学实验室产品生物科技企业。主营产品:试剂盒,ELISA试剂盒,抗体,重组蛋白,血清,胎牛血清,细胞,原代细胞 细胞培养试剂,常用生化试剂。
| 成立日期 | (12年) |
| 注册资本 | 100万元整 |
| 员工人数 | 10-50人 |
| 年营业额 | ¥ 100万以内 |
| 经营模式 | 工厂,试剂,定制,服务 |
| 主营行业 | 生化试剂,细胞培养,蛋白组学,分子生物学,细胞生物学 |
Anti-PLK1 antibody-丝氨酸/苏氨酸蛋白激酶PLK1抗体相关厂家报价
-

- Anti-PLK1:丝氨酸/苏氨酸蛋白激酶Plk1抗体
- 上海冠导生物工程有限公司 VIP
- 2026-04-10
- 询价
-

- 人PLK1(丝氨酸/苏氨酸蛋白激酶PLK1)ELISA试剂盒
- 上海信裕生物科技有限公司 VIP
- 2026-03-19
- ¥1785
-

- PLK1蛋白抗体;PLK1 antibody 艾普蒂生物
- 湖北艾普蒂生物工程有限公司
- 2025-06-04
- ¥1280
-

- 人丝氨酸苏氨酸蛋白激酶(PLK1)ELISA试剂盒 YB71422Hu
- 上海钰博生物科技有限公司 VIP
- 2026-03-26
- ¥1710
-

- 小鼠丝氨酸苏氨酸蛋白激酶(PLK1)ELISA试剂盒
- 上海联迈生物工程有限公司 VIP
- 2026-03-20
- ¥1520